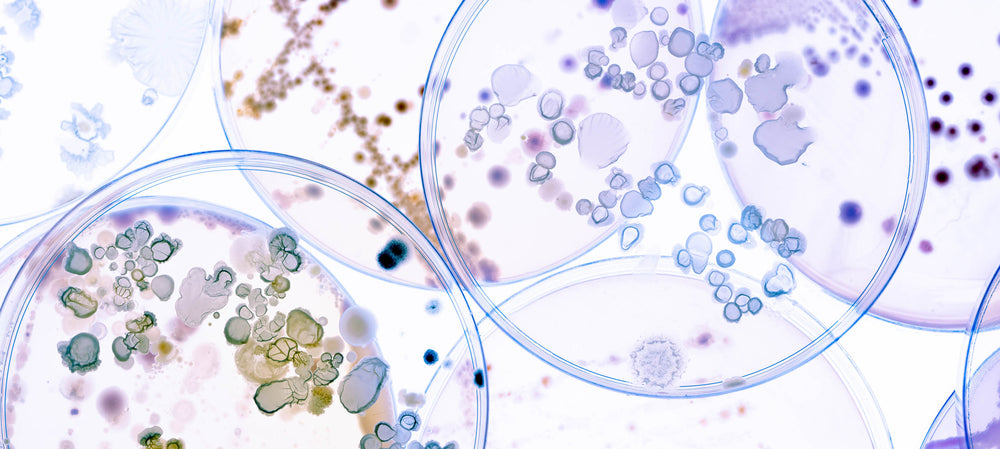

Eye care providers should make it a point to warn contact lens wearers about the potential danger of wearing contacts in the shower.
Acanthamoeba keratitis (AK) is a rare, but extremely serious eye infection that has the potential of causing permanent vision loss. This bacteria can be contracted from bodies of water but also while showering. Acanthamoeba keratitis most commonly occurs in contact lens wearers with contact lens wearers accounting for 85% of the cases.
Acanthamoeba keratitis is extremely difficult to treat with therapies including chemicals that are much like ones used to clean pools and then other ones that are used by surgeons to scrub for surgery. Symptoms of AK include red eyes, eye pain and blurred vision and can easily be misdiagnosed as herpes simplex keratitis. It is important for physicians to consider AK a possibility when dealing with a contact lens wearer with these symptoms.